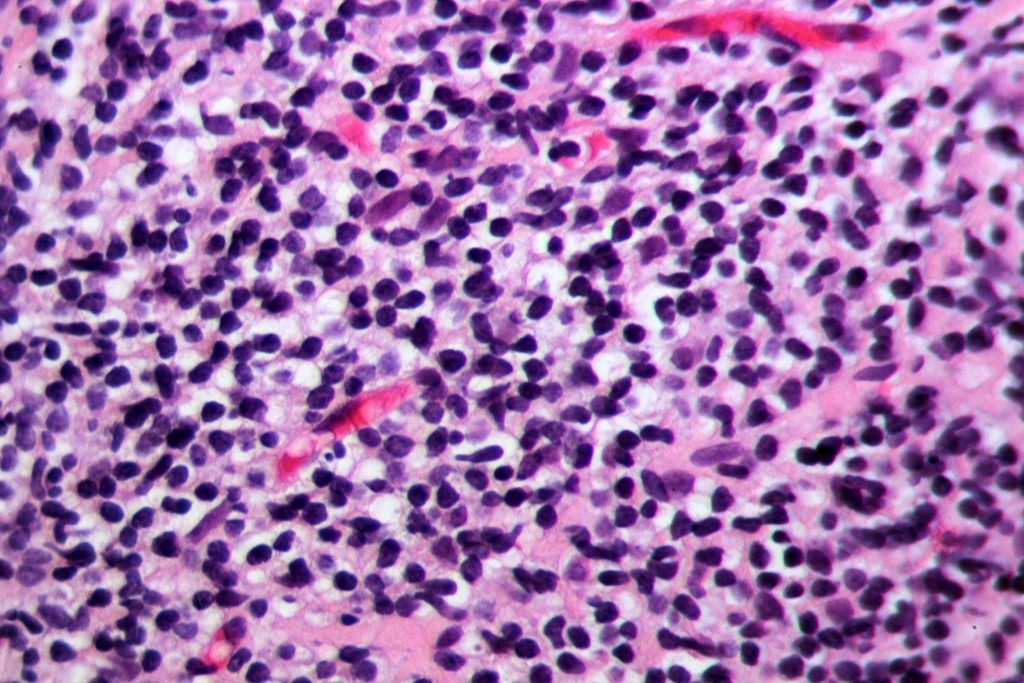
헬리코박터

헬리코박터 파일로리균 검사는 위염과 관련된 주요 원인 중 하나인 헬리코박터 파일로리균의 감염 여부를 확인하기 위해 수행되는 검사입니다. 이 균은 위의 내벽에 침투하여 염증을 일으키고 다양한 위장 질환을 유발하는 원인으로 알려져 있습니다.
헬리코박터 파일로리균 검사에는 여러 가지 방법이 있으며, 주로 사용되는 방법들은 다음과 같습니다
검사 종류
숨김염색법
• 환자가 별도의 특별한 준비 없이 위 내부에서 검체를 채취한 후 현미경으로 살펴보는 방법입니다.
• 해당 검사 방법은 비교적 간단하고 빠르게 수행할 수 있으며, 헬리코박터 파일로리균의 존재 여부를 확인하는 데에 사용됩니다.
항원 검사
• 환자의 대변 또는 호흡기 분비물에서 헬리코박터 파일로리균 항원을 직접 검출하는 방법입니다.
• 증상이 있지만 내시경 검사를 피하고자 할 때나, 다른 검사 방법으로 확실한 결과를 얻지 못할 때 주로 사용됩니다.
기둥세포 검사
• 내시경 검사 중 위 내벽에서 채취한 조직을 기둥세포로 확인하여 헬리코박터 파일로리균의 존재 여부를 확인하는 방법입니다.
• 조직 채취 후 별도의 조직학적 검사를 수행하여 정확한 진단을 내릴 수 있습니다.
검사시간
숨김염색법
• 보통 검체를 채취한 후 현미경으로 확인하는 방법으로 비교적 빠르게 결과를 얻을 수 있습니다.
• 대개 몇 시간에서 하루 이내에 결과를 확인할 수 있습니다.
항원 검사
• 대변 또는 호흡기 분비물 등에서 직접 항원을 검출하는 방법으로, 일반적으로 빠른 시간 내에 결과를 얻을 수 있습니다.
• 주로 몇 시간에서 하루 정도 소요될 수 있습니다.
내시경 검사
• 내시경 검사는 복잡하고 정교한 검사로, 검사 시간은 약 15분에서 30분 정도 소요됩니다.
• 검사 후 조직 채취를 하여 별도의 조직학적 검사를 실시해야 하므로, 결과를 얻는 데에는 1일 이상 소요될 수 있습니다.
기둥세포 검사
• 내시경 검사 중 위 내벽에서 채취한 조직을 기둥세포로 확인하여 헬리코박터 파일로리균의 존재 여부를 확인하는 방법입니다.
• 조직 채취 후 별도의 조직학적 검사를 실시하므로 결과를 얻는 데에는 1일 이상 소요될 수 있습니다.
“헬리코박터 파일로리균 검사”에 대한 1개의 생각